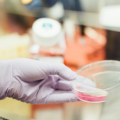

Driven by innovation, the company has revolutionized its medicine production strategies. The dedicated technical team has advanced both existing products and R&D efforts.
Prioritizing quality, we’ve established robust systems to produce world-class products that meet the highest standards for our customers, partners, employees, and communities.
Our state-of-the-art facilities and advanced equipment enable us to manufacture a wide range of high-quality formulations. We offer a diverse product portfolio to meet the needs of our partners with innovative solutions.
Our R&D division drives innovation through scientific rigor and advanced technology. With a culture of curiosity and collaboration, we continually enhance our products and deliver pioneering solutions to meet the evolving needs of our partners and customers.
Our 33,000 sq. ft. GMP & ISO-compliant facility specializes in veterinary formulations for Cattle, Poultry, Aqua, and Canine, offering high-quality contract manufacturing with global reach.
We ensure pure, potent supplements through meticulous sourcing and advanced testing at our state-of-the-art, quality-driven facility.
Our expansive plant is your contract manufacturing hub, delivering scale, efficiency, and global reach for your animal wellness brand.
